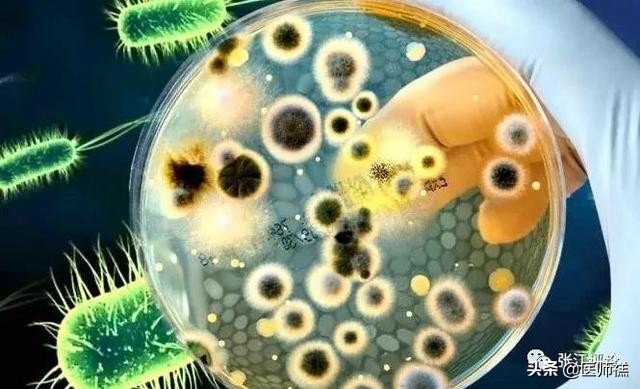
延时*剂喷**到底靠不靠谱，意外怀孕是否对胎儿发育不利？

前一阵子有位粉丝突然问了一个我一个超纲的问题,使用延时*剂喷**类产品导致怀孕会对婴儿的健康造成影响吗?
事后我对这个问题进行了相关的研究,觉得这个事情虽然很冷门但是值得我们探讨一番,所以决定把这个科普要点分享给大家,至于是哪位粉丝我们就不再关注,希望这篇文章可以解决您当下的问题。
延迟类药物与PE
Premature Ejaculation,PE也就是我们俗称的*泄早**, 相信大家并不陌生,它是临床中最常见的一种性功能障碍。

如果你被他困扰到,相信会对你的生理和人际交往造成一定的痛苦和悲痛。当然是否患有此症,并不是我们心理上单纯的以时间长短为标准,临床上对于此病有着严格而科学的评估。那就是PEDT量表,这也是世界上评价PE最常用的量表。结合5个问题的评分细则。就可以评判是否患有此症,如有兴趣的伙伴可以网上搜索自我评估一番,这里不做详细阐述。
我的这位粉丝也是备受PE的困扰,于是选择了延迟类药物作为辅助手段。但是却不小心意外怀孕。那么问题来了,如果我们为了获取时间上的优势,而使用了网上售卖的各种延时产品引发的怀孕, 是否可以继续妊娠?会不会对胎儿造成一定的不良影响呢?
接下来我们详细地谈一谈。
延迟类产品到靠不靠谱
首先延迟类产品在市面是确实存在的,这些产品的存在也是治疗PE的方案之一。例如临床上最先接受的利多卡因-丙胺卡因乳膏或气溶胶,这是治疗PE的最早方案之一。

但是这种治疗方案存在一定的弊端,那就是容易导致神经麻木,丧失快感,甚至有可能导致配偶敏感部位麻木的风险。为此市面上围绕降低敏感度延长时间的同时,还不降低快感,于是各种物理延时和减低神经敏感性的产品开始在市面上大量出现。
不过总的来讲,延迟类产品主要分为针对神经麻痹例如利多卡因等具有麻醉效果的西药成分,以及刺激血液流动降低神经递质传导速度从而达到延迟的植物提取物例如丁香、肾经草、苦参等各种成分。
因此从对症方面延迟类的产品是存在的也是靠谱的。
延迟类产品到底会不会对胎儿造成伤害?
这点相信一定使我们中招的使用者万分的担心。
- 首先我们需要明白延迟类产品所含的成分,他更多的是对我们的皮肤和粘膜造成一定的刺激和损伤。例如含有西药麻醉成分的延迟类产品会刺激神经引发疼痛感减弱,过度猛烈的运动会造成表面皮肤出现过度摩擦增加皮肤损伤风险。

- 此外部分产品中还添加了其他的辅助成分,对部分患者会造成不同程度的致敏反应,因此引发敏感部位的粘膜刺激造成一定的红肿胀痛。

虽然延迟类产品在使用的过程中其实最多涉及到皮肤的刺激和神经传感度降低的层面,并不涉及到引发精子活力降低、运动减弱等方面。因此只要使用正规平台的产品、正确按步骤使用在面对数量庞大的精子数量延迟类产品是无法对生殖细胞造成影响的,也就无法影响后续受精卵的着床和发育过程,是可以继续妊娠的。

不会影响精子与卵子的正常受精
但是如果随意使用三无产品,就要当心其中是否含有有毒有害物质,例如汞、铅、砷、镉、甲醇等成分,就需要考虑对粘膜和生殖部位造成不可估量的损伤情况。
因此此类产品在正式进入市场之前除了需要一定的变态过敏反应测试,以及男女性敏感部位的粘膜刺激试验外,更重要的是对产品进行全放的安全检测,只有当这些试验全部通过以后才可能会进一步流入市场,提供给消费者。

延迟类产品还存在哪些弊端?
- 首先针对延迟类产品并目前并没有正式的国家标准出台,很多平台售卖的延迟类产品一般多经过第三方检测机构的认证,甚至有些平台的判定标准是平台自己制作的在权威性方面此类产品的质量认证还存在一定的欠缺。

- 其次此类产品在检测方面多存在避重就轻的情况。例如多针对微生物指标进行检测,这其中的原因主要是使用的部位多接触皮肤和粘膜,主要规避感染的情况。但是对延迟产品的使用量和安全性方面缺乏一定的评判标准。例如很多检测机构的报告上面过多的体现大肠杆菌、金黄色葡萄球菌、真菌、细菌总数等指标进行检测,但是很少涉及外用延时剂中是否有贡、砷、甲醛等有毒有害成分、是否存在利多卡因、苯佐卡因等神经麻痹类成分。避重就轻地检测后就匆匆流入市场,势必会对消费者造成一定的健康损伤。但就目前而言质量标准控制较好的要数京东平台的《京东外用延时剂产品质量标准》,其在控制有毒有害指标、禁用神经麻醉指标、微生物指标方面均有一个很好的把控。
- 最后,延迟类产品始终是治标不治本,虽然目前有很多的中成药植物提取成分可以有效的延迟时间且避免对皮肤造成刺激。但是长期使用也很容易形成依赖,若被配偶发现很大程度上会对使用者在生理和心理层面造成一定的影响,有可能加重PE的症状。
面对PE我们又该如何治疗呢?
- 目前临床上针对PE的治理方式有很多,借助正规渠道的延迟类产品也是可以作为一种治疗方案的。由于延迟类产品可以在短时间内改善PE症状,有利于给使用者提供一个良好的环境,改善不良心理,提高性的生活质量。

- 第二个最常见的就是手术治疗了,以包皮环切术、经皮单侧阴茎背神经冷冻消融术最为常见。由于PE患者的神经反射阈值较低,在去除包皮处敏感丰富的神经,有利于延长患者勃起时间,治疗PE。但是目前的临床数据显示包皮环切术的有效性还有待一定的考究,主要是因为术后PE的患病率降低程度并不明显。但是经皮单侧阴茎背神经冷冻消融术的效果尤为显著,其主要功效在于减弱了患者极为敏感的神经数,降低了神经冲动。但是这种情况也因人而异,不同患者的反馈也不尽相同。

- 第三种就是行为疗法:所谓行为疗法一般是指先暴露,后放松在激活的训练行为方式 。对于PE的患者,可以通过掌握一定的刺激技巧来延迟相应的时间。这种方法的有点在与它可以 增加患者的自信心,有助于减缓我们在面对特定的情形时候所产生的焦虑喝紧张情绪。 因此心理治疗尤为关键,特别是配偶之间的相互理解和配合,加以“停-动”结合的挤压敏感焦点训练,是可以纳入治疗范畴的。 但是行为缺点有一个弊端 就是很难去评价这种方法的有效性,效果会因人而异因家庭情况而异。同时这种方法 起效缓慢,治疗周期长,也很容易复发,效果不稳定。

- 第四种就是新研发的治疗方案,例如催产素受体拮抗剂的使用。催产素是一种肽激素,这些激素具有良好的中心穿透性和快速吸收的小分子,具有 有效的催产素受体拮抗作用。在动物模型中,它可通过中枢和外周途径来缩短射精潜伏时间。但是这种方案仅停留在动物试验层面,面对人体实验还有很多的路要走。

总之PE治疗方法多种多样,各治疗方法均有其不同的利弊,在临床诊治中,我们一定要综合患者发病原因、心理、经济条件等选择最适合于患者的治疗方法,这样才可以早日为患者解决痛苦。
总结
总结:延迟产品目前鱼龙混杂,如果我们需要此类产品的辅助治疗那么一定要在正规平台购买官方认证的产品,切莫随意使用三无产品,安全卫生的延迟产品是不会影响胎儿受精以及发育的。但是由于怀孕过程的复杂性和我们使用产品的质量不确定性,要求我们在使用相关产品的时候一定要慎重,切莫让有毒有害的成分对自身和对方甚至未来的胎儿造成不可评估的影响,使用产品的时候最好可以与配偶坦诚相待一起来面对这个问题。
参考文献:
1、丁永强 ,李荣欣.*泄早**的治疗现状及进展[J]男科与性医学,2019,10 (28) :28-31。
2、京东,深圳市计量质量检测研究院:《京东外用延时剂产品质量标准》